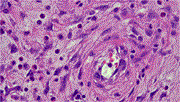

Issue navigation
Volume 2025, Issue 6, June 2025
Case Reports
An eight-year asymptomatic retention of a knife blade in the chest: a case report
Nashivai Kivuyo and others
Journal of Surgical Case Reports, Volume 2025, Issue 6, June 2025, rjaf325, https://doi.org/10.1093/jscr/rjaf325
Gastrointestinal stromal tumor of the small intestine presenting as a giant intratumoral abscess: a rare case report
Saleh Husam Aldeligan and others
Journal of Surgical Case Reports, Volume 2025, Issue 6, June 2025, rjaf344, https://doi.org/10.1093/jscr/rjaf344
Case report: right radical nephrectomy with thrombectomy in a patient with renal tumor, retrohepatic inferior vena cava agenesis, and tumor extension to the azygos vein
Mateo B Nolfi and others
Journal of Surgical Case Reports, Volume 2025, Issue 6, June 2025, rjaf351, https://doi.org/10.1093/jscr/rjaf351
Urachal cyst: a rare cause of an abdominal mass in a Ghanaian adult female: a case report
Ishmael Kyei and others
Journal of Surgical Case Reports, Volume 2025, Issue 6, June 2025, rjaf356, https://doi.org/10.1093/jscr/rjaf356
Case report: a case of foramen of Winslow hernia causing portal venous compression
Caroline M Yang and others
Journal of Surgical Case Reports, Volume 2025, Issue 6, June 2025, rjaf357, https://doi.org/10.1093/jscr/rjaf357
Phytobezoar mimicking superior mesenteric artery syndrome in acute duodenal obstruction: a case report and review of literature
Daniel Ho and Christopher B Nahm
Journal of Surgical Case Reports, Volume 2025, Issue 6, June 2025, rjaf358, https://doi.org/10.1093/jscr/rjaf358
Advanced squamous cell carcinoma with myiasis: a case report
Ali Adwal Ali and others
Journal of Surgical Case Reports, Volume 2025, Issue 6, June 2025, rjaf263, https://doi.org/10.1093/jscr/rjaf263
A first of its kind: iliacus hernia containing an inflamed appendix
Aulon Jerliu and others
Journal of Surgical Case Reports, Volume 2025, Issue 6, June 2025, rjaf362, https://doi.org/10.1093/jscr/rjaf362
Clinical characteristics and surgical management of ileal strictures caused by ischemic enteritis: a report of three cases
Yuya Kondo and others
Journal of Surgical Case Reports, Volume 2025, Issue 6, June 2025, rjaf363, https://doi.org/10.1093/jscr/rjaf363
Management of a life-threatening esophageal perforation during laparoscopic sleeve gastrectomy: a case study of an Ecuadorian patient
Bernarda Patiño-Araujo and others
Journal of Surgical Case Reports, Volume 2025, Issue 6, June 2025, rjaf370, https://doi.org/10.1093/jscr/rjaf370
Conglomerate of inguinal lymphadenopathies mimicking a strangulated hernia: a case report and review of imaging necessity
Tarik Deflaoui and others
Journal of Surgical Case Reports, Volume 2025, Issue 6, June 2025, rjaf371, https://doi.org/10.1093/jscr/rjaf371
Bilateral pulmonary parenchymal metastasis from a low-grade appendiceal mucinous neoplasm
John D M Cavaye and others
Journal of Surgical Case Reports, Volume 2025, Issue 6, June 2025, rjaf367, https://doi.org/10.1093/jscr/rjaf367
Navigating anatomical challenges of minimally invasive mitral valve replacement in a patient with severe scoliosis
Henri Bartolozzi and others
Journal of Surgical Case Reports, Volume 2025, Issue 6, June 2025, rjaf369, https://doi.org/10.1093/jscr/rjaf369
Acute phlegmonous appendicitis with deciduosis: a case report and literature review
Takuya Shimogawa and others
Journal of Surgical Case Reports, Volume 2025, Issue 6, June 2025, rjaf375, https://doi.org/10.1093/jscr/rjaf375
Sebaceous lymphadenoma of the parotid: a rare case report of an entity mimicking other salivary tumors
Amine Oussalem and others
Journal of Surgical Case Reports, Volume 2025, Issue 6, June 2025, rjaf382, https://doi.org/10.1093/jscr/rjaf382
Ascending cholangitis in gastric bypass patients following hepatobiliary scintigraphy and oral protein shake administration: a case report
Mahmoud K Abd-El-Hafez and others
Journal of Surgical Case Reports, Volume 2025, Issue 6, June 2025, rjaf365, https://doi.org/10.1093/jscr/rjaf365
Management of a complex pelvic ring fracture in a polytrauma patient: a two-stage approach
Leonardo V Coelho and others
Journal of Surgical Case Reports, Volume 2025, Issue 6, June 2025, rjaf368, https://doi.org/10.1093/jscr/rjaf368
Intrapulmonary migration of a Kirschner wire 12 years after clavicular fracture fixation: case report and review of literature
Robbe Van Dyck and Georges Decker
Journal of Surgical Case Reports, Volume 2025, Issue 6, June 2025, rjaf377, https://doi.org/10.1093/jscr/rjaf377
No mesh, no problem: an innovative surgical approach to a primary superior lumbar hernia repair
Calvin D De Louche and others
Journal of Surgical Case Reports, Volume 2025, Issue 6, June 2025, rjaf386, https://doi.org/10.1093/jscr/rjaf386
Emergency total gastrectomy for gastric perforation secondary to metastatic lobular breast cancer: a case for aggressive surgical intervention in select patients
Amirpasha Rafizadeh and others
Journal of Surgical Case Reports, Volume 2025, Issue 6, June 2025, rjaf387, https://doi.org/10.1093/jscr/rjaf387
Challenges of Cushing's syndrome and bariatric surgery: a case report with literature review
Shaho F Ahmed and others
Journal of Surgical Case Reports, Volume 2025, Issue 6, June 2025, rjaf366, https://doi.org/10.1093/jscr/rjaf366
Ileo-ileal intussusception due to Vanek’s tumor: a rare cause of small bowel obstruction
Islam Rajab and others
Journal of Surgical Case Reports, Volume 2025, Issue 6, June 2025, rjaf383, https://doi.org/10.1093/jscr/rjaf383
Two-stage surgical correction of L4/5 non-union using ALIF and endoscopic TLIF cage removal: a case report
Ralph J Mobbs
Journal of Surgical Case Reports, Volume 2025, Issue 6, June 2025, rjaf385, https://doi.org/10.1093/jscr/rjaf385
Early rupture of a tetrafluoroethylene loop due to fixation with polypropylene resulting in recurrent mitral valve regurgitation; a word of caution
Keijiro Mitsube and others
Journal of Surgical Case Reports, Volume 2025, Issue 6, June 2025, rjaf393, https://doi.org/10.1093/jscr/rjaf393
Gastric duplication cyst in an adult woman: a case report
Samuel Hernández-Alvarado and others
Journal of Surgical Case Reports, Volume 2025, Issue 6, June 2025, rjaf324, https://doi.org/10.1093/jscr/rjaf324
An unusual case of isolated brain metastasis with impending brain herniation from sigmoid colon cancer: case report and review of literature
Ali Toffaha and others
Journal of Surgical Case Reports, Volume 2025, Issue 6, June 2025, rjaf394, https://doi.org/10.1093/jscr/rjaf394
Giant metastasis to the choroid plexus of papillary thyroid cancer: case report and review of the literature
Daniel Alejandro Vega-Moreno and others
Journal of Surgical Case Reports, Volume 2025, Issue 6, June 2025, rjaf396, https://doi.org/10.1093/jscr/rjaf396
A creative approach to the diagnosis and treatment of low back pain: case report and review of the literature
Megan M Finneran and others
Journal of Surgical Case Reports, Volume 2025, Issue 6, June 2025, rjaf403, https://doi.org/10.1093/jscr/rjaf403
Synchronous presentation of Hodgkin lymphoma and papillary thyroid carcinoma in a young patient: a case review
Saleh Husam Aldeligan and others
Journal of Surgical Case Reports, Volume 2025, Issue 6, June 2025, rjaf398, https://doi.org/10.1093/jscr/rjaf398
Adenomyoepithelioma of the breast: a challenging diagnosis on biopsy—case report and literature review
Imane Tazi and others
Journal of Surgical Case Reports, Volume 2025, Issue 6, June 2025, rjaf372, https://doi.org/10.1093/jscr/rjaf372
Hepatic rupture as a life-threatening emergency and rare complication of CPR with the CORPULS device
Tomás Marín-Cuartas and others
Journal of Surgical Case Reports, Volume 2025, Issue 6, June 2025, rjaf409, https://doi.org/10.1093/jscr/rjaf409
Exuberant delayed granulomatous reaction to hyaluronic acid filler material
Nasser Almadan and others
Journal of Surgical Case Reports, Volume 2025, Issue 6, June 2025, rjaf395, https://doi.org/10.1093/jscr/rjaf395
Esophageal perforation more than one year following anterior cervical spinal surgery
Grace R Fassina and others
Journal of Surgical Case Reports, Volume 2025, Issue 6, June 2025, rjaf399, https://doi.org/10.1093/jscr/rjaf399
Peri-renal metastasis of cervical neuroendocrine carcinoma: a case report and literature review
Nopparuj Sangnoppatham and others
Journal of Surgical Case Reports, Volume 2025, Issue 6, June 2025, rjaf412, https://doi.org/10.1093/jscr/rjaf412
Early-to-mid onset bacterial endocarditis following implantation of Gore Cardioform Septal Occluder device
Mahmoud K Abd-El-Hafez and others
Journal of Surgical Case Reports, Volume 2025, Issue 6, June 2025, rjaf414, https://doi.org/10.1093/jscr/rjaf414
Anesthetic planning and management for successful separation surgery of pygopagus conjoined twins: a multidisciplinary approach
Zehra Özgen and others
Journal of Surgical Case Reports, Volume 2025, Issue 6, June 2025, rjaf320, https://doi.org/10.1093/jscr/rjaf320
Unlabeled topical anesthetic-induced severe methemoglobinemia in a pediatric burn patient
Christopher Mahir and others
Journal of Surgical Case Reports, Volume 2025, Issue 6, June 2025, rjaf334, https://doi.org/10.1093/jscr/rjaf334
Papillary and medullary thyroid carcinoma with a single hybrid lymph node: a case report with review of literature
Ari M Abdullah and others
Journal of Surgical Case Reports, Volume 2025, Issue 6, June 2025, rjaf389, https://doi.org/10.1093/jscr/rjaf389
Aggressive leiomyosarcoma of the oral cavity: a rare case report
Amine Oussalem and others
Journal of Surgical Case Reports, Volume 2025, Issue 6, June 2025, rjaf404, https://doi.org/10.1093/jscr/rjaf404
Open repair of iatrogenic complete aortic occlusion during robotic right nephrectomy: a case report
Faisal Almudaiheem and others
Journal of Surgical Case Reports, Volume 2025, Issue 6, June 2025, rjaf405, https://doi.org/10.1093/jscr/rjaf405
Aspergillus aortitis in a patient presenting with bilateral acute lower limb ischemia
Eslam Metwalli and others
Journal of Surgical Case Reports, Volume 2025, Issue 6, June 2025, rjaf418, https://doi.org/10.1093/jscr/rjaf418
Abdominal tuberculosis in a patient with ankylosing spondylitis and infliximab: is the risk still too great? A case report
Miguel Ángel Moyón and others
Journal of Surgical Case Reports, Volume 2025, Issue 6, June 2025, rjaf422, https://doi.org/10.1093/jscr/rjaf422
Spontaneous rupture of the urinary bladder misdiagnosed as gastrointestinal perforation: a diagnostic pitfall in post-radiation patients
Shunya Kiriyama and others
Journal of Surgical Case Reports, Volume 2025, Issue 6, June 2025, rjaf425, https://doi.org/10.1093/jscr/rjaf425
Unexpected journey: a colon adenocarcinoma metastatic to the heart
Elias Edward Lahham and others
Journal of Surgical Case Reports, Volume 2025, Issue 6, June 2025, rjaf379, https://doi.org/10.1093/jscr/rjaf379
A case of aberrant right adrenal vein anatomy
Danielle Humphries and others
Journal of Surgical Case Reports, Volume 2025, Issue 6, June 2025, rjaf401, https://doi.org/10.1093/jscr/rjaf401
A shot to the gut: appendicitis triggered by retained buckshot
Georges Kaoukabani and others
Journal of Surgical Case Reports, Volume 2025, Issue 6, June 2025, rjaf423, https://doi.org/10.1093/jscr/rjaf423
Case report and literature review of gallbladder paraganglioma in patient with inflammatory bowel disease
Matea Dominkovic and others
Journal of Surgical Case Reports, Volume 2025, Issue 6, June 2025, rjaf426, https://doi.org/10.1093/jscr/rjaf426
Intussusception following feeding jejunostomy in a post-esophagectomy patient: a rare complication and its surgical management
Karthik Sri Prasanna Selvaraj and others
Journal of Surgical Case Reports, Volume 2025, Issue 6, June 2025, rjaf427, https://doi.org/10.1093/jscr/rjaf427
Early recurrent midgut volvulus post Ladd’s procedure in a newborn: a case report
Nicole Clarke and others
Journal of Surgical Case Reports, Volume 2025, Issue 6, June 2025, rjaf428, https://doi.org/10.1093/jscr/rjaf428
Delayed diagnosis of type I jejunal atresia in an infant with intractable vomiting: a case report
Hadjar Nassiri and others
Journal of Surgical Case Reports, Volume 2025, Issue 6, June 2025, rjaf429, https://doi.org/10.1093/jscr/rjaf429
A rare case of right proximal subclavian artery aneurysm: a case report
Dianzhu Ding and others
Journal of Surgical Case Reports, Volume 2025, Issue 6, June 2025, rjaf430, https://doi.org/10.1093/jscr/rjaf430
Pineal region collision tumor
Petar Marčinković and others
Journal of Surgical Case Reports, Volume 2025, Issue 6, June 2025, rjaf432, https://doi.org/10.1093/jscr/rjaf432
A novel case of aripiprazole and clomipramine-induced toxic megacolon: enough to drive anyone mad
Taylor J Casey and Britton P Mehr
Journal of Surgical Case Reports, Volume 2025, Issue 6, June 2025, rjaf265, https://doi.org/10.1093/jscr/rjaf265
Posterior trachea wall erosion: a case report and literature review of a catastrophic complication of cuff overinflation
Zahraa Almuhanna and others
Journal of Surgical Case Reports, Volume 2025, Issue 6, June 2025, rjaf361, https://doi.org/10.1093/jscr/rjaf361
Gastric duplication cyst or pancreatic pseudocyst: a diagnostic dilemma
Dhruv Gandhi and others
Journal of Surgical Case Reports, Volume 2025, Issue 6, June 2025, rjaf373, https://doi.org/10.1093/jscr/rjaf373
A rare case of stent graft-related endoleak during follow-up of aortic arch aneurysm F/B TEVAR
Miao Li and others
Journal of Surgical Case Reports, Volume 2025, Issue 6, June 2025, rjaf419, https://doi.org/10.1093/jscr/rjaf419
The role of comorbidities in a rare case of sequential atraumatic lateral malleolus fractures
Danil V Chernov and others
Journal of Surgical Case Reports, Volume 2025, Issue 6, June 2025, rjaf437, https://doi.org/10.1093/jscr/rjaf437
Successful reduction of an obturator hip dislocation using flexion, abduction, and external rotation: a case report
Yudai Yokota and others
Journal of Surgical Case Reports, Volume 2025, Issue 6, June 2025, rjaf438, https://doi.org/10.1093/jscr/rjaf438
Struma ovarii mimicking ovarian malignancy: a case report
Giulia Bruni and others
Journal of Surgical Case Reports, Volume 2025, Issue 6, June 2025, rjaf439, https://doi.org/10.1093/jscr/rjaf439
A rare case of uterine lipoleiomyoma initially suspected as sarcoma in a 49-year-old woman
Karmen Saroufine and others
Journal of Surgical Case Reports, Volume 2025, Issue 6, June 2025, rjaf440, https://doi.org/10.1093/jscr/rjaf440
Neuroendocrine carcinomas of the larynx: a review of current literature and case analysis
Ingrid Raponi and others
Journal of Surgical Case Reports, Volume 2025, Issue 6, June 2025, rjaf410, https://doi.org/10.1093/jscr/rjaf410
Surgical treatment of ankylosing spondylitis with Andersson lesion in the thoracic spine: a case report and review of the literature
Lei Yang and others
Journal of Surgical Case Reports, Volume 2025, Issue 6, June 2025, rjaf436, https://doi.org/10.1093/jscr/rjaf436
Superior mesenteric vein thrombosis as uncommon complication following laparoscopic sleeve gastrectomy: a case report and literature review
Mones H Atatre and others
Journal of Surgical Case Reports, Volume 2025, Issue 6, June 2025, rjaf441, https://doi.org/10.1093/jscr/rjaf441
Splenic rupture secondary to diverticulitis: a case report
Muhi Dean Barazi and others
Journal of Surgical Case Reports, Volume 2025, Issue 6, June 2025, rjaf442, https://doi.org/10.1093/jscr/rjaf442
Capillary hemangioma of the maxillary sinus: diagnostic challenges and endoscopic surgical outcomes – a rare case report from Syria
Mais Alreem Basel Mohaisen and others
Journal of Surgical Case Reports, Volume 2025, Issue 6, June 2025, rjaf443, https://doi.org/10.1093/jscr/rjaf443
Meat bezoar-induced small bowel obstruction: a rare but critical cause of acute intestinal distress
Yassine El Bouazizi and others
Journal of Surgical Case Reports, Volume 2025, Issue 6, June 2025, rjaf448, https://doi.org/10.1093/jscr/rjaf448
Case report of a splenectomy secondary to infectious mononucleosis in a 16-year-old female
George G Wilson and Kelly Rennie
Journal of Surgical Case Reports, Volume 2025, Issue 6, June 2025, rjaf420, https://doi.org/10.1093/jscr/rjaf420
Giant omental lipoma arising from broad ligament mimicking as adnexal mass: a diagnostic dilemma
Nishan Subedi and Niharika Joshi
Journal of Surgical Case Reports, Volume 2025, Issue 6, June 2025, rjaf450, https://doi.org/10.1093/jscr/rjaf450
Concomitant incarcerated right direct inguinal hernia and right femoral hernia in a male patient: a case report
Aseel Shams and others
Journal of Surgical Case Reports, Volume 2025, Issue 6, June 2025, rjaf391, https://doi.org/10.1093/jscr/rjaf391
Cobb syndrome: an interdisciplinary approach between neurosurgery and dermatology – case report and review of the literature
Jason Riveros-Ruiz and others
Journal of Surgical Case Reports, Volume 2025, Issue 6, June 2025, rjaf411, https://doi.org/10.1093/jscr/rjaf411
Persistent hypokalemia due to Conn’s syndrome resolved by robot-assisted laparoscopic adrenalectomy. A correct diagnostic approach for proper surgical therapy. Case report
Santiago Muñoz-Palomeque and others
Journal of Surgical Case Reports, Volume 2025, Issue 6, June 2025, rjaf446, https://doi.org/10.1093/jscr/rjaf446
Long-term survival after extended resection combined with pericardiectomy for locally advanced intrahepatic cholangiocarcinoma: a case report
Kit-Fai Lee and others
Journal of Surgical Case Reports, Volume 2025, Issue 6, June 2025, rjaf454, https://doi.org/10.1093/jscr/rjaf454
Spontaneous steinstrasse—a rare clinical case report
Nikolay Dimov and others
Journal of Surgical Case Reports, Volume 2025, Issue 6, June 2025, rjaf455, https://doi.org/10.1093/jscr/rjaf455
Recurrent hiatal hernia causing small bowel obstruction secondary to herniation into right hemithorax following prior esophagectomy: a case report
Peculiar A Ihunwo and others
Journal of Surgical Case Reports, Volume 2025, Issue 6, June 2025, rjaf381, https://doi.org/10.1093/jscr/rjaf381
Cutaneous sarcomatoid squamous cell carcinoma of the scalp: a case report
Agnes Nampijja and others
Journal of Surgical Case Reports, Volume 2025, Issue 6, June 2025, rjaf456, https://doi.org/10.1093/jscr/rjaf456
Pilomatricoma of the elbow
Youssef El Hassnaoui and others
Journal of Surgical Case Reports, Volume 2025, Issue 6, June 2025, rjaf457, https://doi.org/10.1093/jscr/rjaf457
Ileocolic intussusception as the initial presentation of Burkitt lymphoma in a 27-year-old male: a case report
Jacob E Chinthagada and others
Journal of Surgical Case Reports, Volume 2025, Issue 6, June 2025, rjaf460, https://doi.org/10.1093/jscr/rjaf460
A novel approach for maintaining alignment of sigmoid vaginoplasty anastomosis of urogenital sinus repair complicated with iatrogenic rectovaginal fistula: case report
Abubakr H Mossa and others
Journal of Surgical Case Reports, Volume 2025, Issue 6, June 2025, rjaf466, https://doi.org/10.1093/jscr/rjaf466
Case Series
Reconstruction facial sequelaes of NOMA with anterolateral thigh free flap: two case reports
Phan Tuấn Nghĩa and others
Journal of Surgical Case Reports, Volume 2025, Issue 6, June 2025, rjaf354, https://doi.org/10.1093/jscr/rjaf354
Primary anorectal melanoma: report of two cases
Ever Frank Lopez-Cutipa and others
Journal of Surgical Case Reports, Volume 2025, Issue 6, June 2025, rjaf376, https://doi.org/10.1093/jscr/rjaf376
Gastroesophageal junction pancreatic heterotopia/metaplasia: a case series
Moaaz Amir and Salwa Sheikh
Journal of Surgical Case Reports, Volume 2025, Issue 6, June 2025, rjaf390, https://doi.org/10.1093/jscr/rjaf390
Surgical treatment experiences in two cases of spontaneous esophageal ruptures
Baoxiang Pei and others
Journal of Surgical Case Reports, Volume 2025, Issue 6, June 2025, rjaf406, https://doi.org/10.1093/jscr/rjaf406
Real-time transrectal ultrasound-guided transurethral resection of prostate cyst: a novel technique and initial clinical experience
Fu-Xiang Lin and others
Journal of Surgical Case Reports, Volume 2025, Issue 6, June 2025, rjaf407, https://doi.org/10.1093/jscr/rjaf407
Guide wire misadventure: a duo of inadvertent intravascular migration
Peter O Adeoye and others
Journal of Surgical Case Reports, Volume 2025, Issue 6, June 2025, rjaf431, https://doi.org/10.1093/jscr/rjaf431
Our approach to endoscopic septoplasty: Intra Nasal Endoscopic Septoplasty with NOSE score analysis
Nader Alharbi and others
Journal of Surgical Case Reports, Volume 2025, Issue 6, June 2025, rjaf453, https://doi.org/10.1093/jscr/rjaf453
Surgical Technique
Traction-assisted chest elevation (TRACE)—a novel technique for improving intraoperative ergonomics in endoscopic mastectomy
Thaddaeus Jun Kiat Tan and others
Journal of Surgical Case Reports, Volume 2025, Issue 6, June 2025, rjaf321, https://doi.org/10.1093/jscr/rjaf321
Innovative approaches to dog-ear deformities in burn contracture release surgery: preserving skin for functional and aesthetic outcomes
Mehdi Ayaz and Dorsa Ayaz
Journal of Surgical Case Reports, Volume 2025, Issue 6, June 2025, rjaf360, https://doi.org/10.1093/jscr/rjaf360
“The Three Gorges” flap based on three tributaries—the bilateral deep inferior epigastric, superficial circumflex and external pudendal systems
Nadia Hui Shan Sim and Allen Wei-Jiat Wong
Journal of Surgical Case Reports, Volume 2025, Issue 6, June 2025, rjaf408, https://doi.org/10.1093/jscr/rjaf408
Correction
Correction to: Complex postoperative ureterovaginal and vesicovaginal fistula following a non-oncological hysterectomy: a report of a challenging complication
Journal of Surgical Case Reports, Volume 2025, Issue 6, June 2025, rjaf424, https://doi.org/10.1093/jscr/rjaf424
Advertisement
New and popular articles
Advertisement